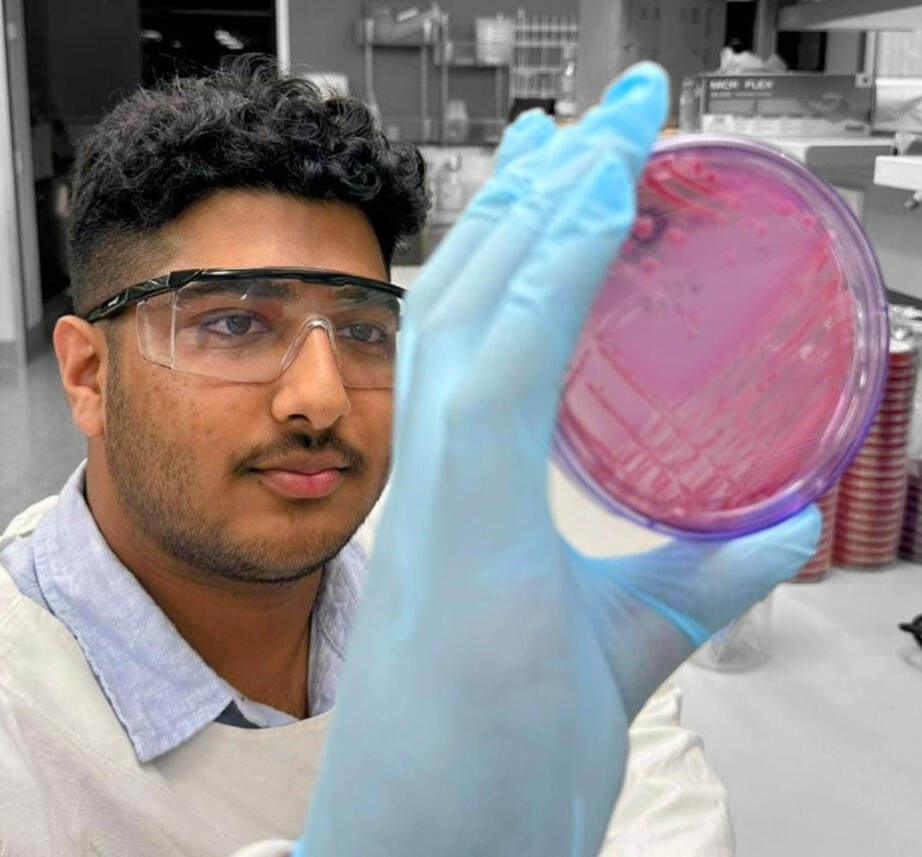

landing page
Akira etipola
Hey!
My name's Akira Etipola, and I've got this small corner of the Internet to express myself and my contacts!

Who Am I?
I'm currently a Biomedical Science and Microbiology Student from the University of Queensland.My personal interests include technology, cars, reading, watches, and sports such as F1 and Football.My scholarly interests revolve around infectious diseases and microbiology, but also include similar fields such as pathology, tropical medicine, and public health.

CURRENT SCHOLARLY PROJECTS
Some of the research projects that I am currently involved in include:• Comparative analysis of commercial DNA extraction kits for isolation and detection of Burkholderia pseudomallei genomic DNA from spiked whole blood• Rapid diagnosis of Burkholderia pseudomallei from spiked whole blood using a metagenomics approachIf you have any questions about this, or would like to collaborate, please do not hesitate to contact me.
Skills
As you can see from my About Me page, I've got a lot on my plate! It's because I intrinsically believe that the more skills you have, the more valuable you are to society. Some of my key skills are listed below, feel free to have a read!
• Time and Task Management
As a student, I understand how crucial organisation and task management is. Having managed to undertake full time University, a Certificate III, volunteering, fitness commitments such as gym and martial arts, as well as a social life attests to my excellent skills in organising work schedules and task prioritisation.• Laboratory and Pathology Duties
As a Science Student, I have encompassed an appreciation for ethical considerations, scientific communication, collaboration, attention to detail, and the scientific method.From my Certificate III and current occupation as a Pathology Lab Assistant, I can demonstrate procedures of pathology collection and assistance.To complement this, my university practicals have refined my wet and dry lab skills to a high degree too, such as conducting wet lab experiments, analysing literature in preparation for ethics submissions, writing up research proposals and article reviews, and operating laboratory equipment (e.g. centrifuges, PCR thermocyclers, sonicators, etc.)• Taking Initiative/Eagerness
I'm always eager to experience new things and pursue outside my comfort zone.
Volunteer Work
For me, not everything is about making those $ signs. I try to help out others for free where possible as well. Below are a few of the volunteering exercises that I've participated in.
• Vital Connections
I've conducted stall promotions and sold baked goods in exchange for hygienic products for the homeless and poor.• World’s Greatest Shave
I participated in the World’s Greatest Shave thrice, which involved shaving off my hair to raise awareness for Leukaemia and fund blood cancer research.• University Club Roles
I was the past social media manager for The UQ Backyard Sports Association (UQBSA), UQ Association of Biomedical Students (UQABS) Industry Events Officer, External Relations Exec for UQ Red Cross Society (UQRCS), Sponsorship Exec for UQ Sri Lankan Association (UQSLA) and General Exec for UQ Premedical Society.• Mater Volunteer
I am currently a volunteer patient companion in the Mater Hospital Emergency Department, assisting patients with their non-clinical needs in a ward setting. Moreover, I am also a Simulation Patient for healthcare professionals, which Mater Health Services uses as a tool in the provision of safe quality patient care.
Contact
If you want to contact me, you can either fill out the below email form or press on the social media buttons!
Thank you
Thanks for reaching out! I'll reply as soon as possible.